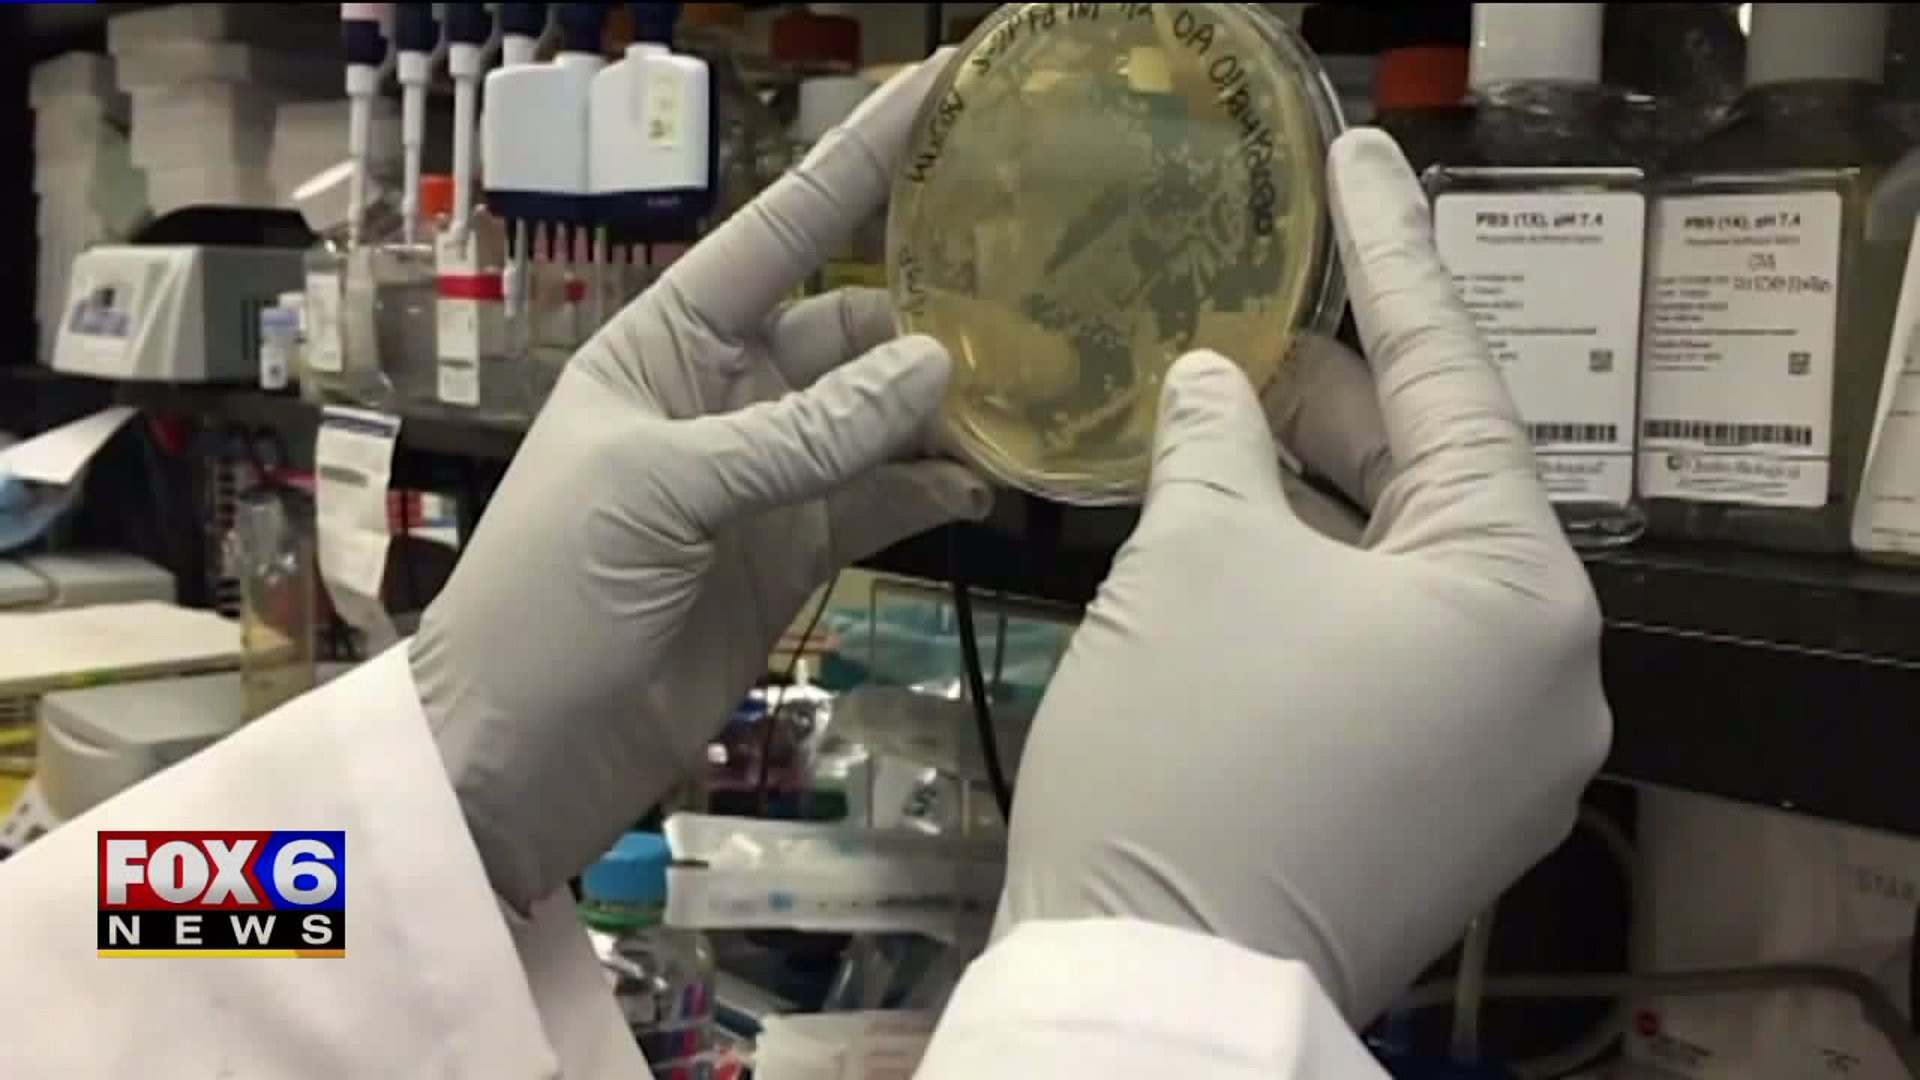

Increase in Milwaukee County coronavirus testing
Increase in Milwaukee County coronavirus testing
Top Videos
Increase in Milwaukee County coronavirus testing

What's next for Ridglan Farm beagles?

USPS delays causing problems for Wisconsin small business

Man accused of trafficking UWM student

Drivers feeling gas price surge

Rescue groups pay for release of 1,500 dogs

Wisconsin Weather Experts: Chance for scattered showers

Milwaukee I-794: Public weighs in on options

Exclusive interview with Wayne Pacelle

FOX6 Investigators have exclusive interview with Lauree Simmons

Doctor discusses alcohol consumption, addiction

May Day demonstrations in Milwaukee, Waukesha

Menomonee Falls gas station shootout; 2 brothers accused

Glendale street takeover police chase, Illinois man charged

Ridglan Farms beagles starting to be released

Milwaukee apartment fire; 5 jump, 6 rescued

Milwaukee apartment building fire on Fond du Lac Ave

Fisher House on Milwaukee VA campus celebrates 10 years

King Charles, Queen Camilla 4-day visit to the US

Pettit National Ice Center goes solar

Lake Express Ferry begins 2026 season

Milwaukee apartment building fire

Milwaukee Fire Department provided update on apartment fire

Ridglan Farms beagles: Humane Society gets involved

Ridglan Farms beagles: Update from FOX6 Investigators


